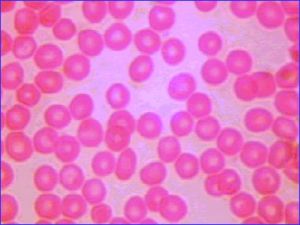
含鐵紅細胞

簡介
含鐵紅細胞指含有大量或少量鐵紅蛋白的細胞,鐵紅蛋白是細胞造血過程中不可缺少的物質,其含量的高低也決定細胞的造血功能的強弱.
相關介紹
精神分裂症的紅細胞和血清含鐵量的測定結果及分析
摘 要:目的為了解精神分裂症患者紅細胞內外鐵含量的變化。方法對53例精神分裂症患者及50例正常對照者測定紅細胞及血清鐵水平進行對照。結果紅細胞及血清鐵水平均較對照組增高(P〈0.01);病程≥3年患者較〈3年者紅細胞鐵呈增高趨勢,而血清鐵則呈下降趨勢;紅細胞及血清鐵水平間無相關性(P〉0.05)。結論:本實驗提示精神分裂症患者體記憶體在著鐵代謝異常,並對其臨床意義進行了初步探討。